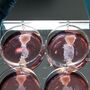
Mais de 60% dispostos a experimentar carne de laboratório

A Newsletter SÁBADO Edição Manhã no seu e-mail
Tudo o que precisa de saber sobre o que está a acontecer em Portugal e no mundo.
Enviada de segunda a domingo às 10h30
- Portugal
- Mundo
- Dinheiro
- Ciência & Saúde
- Opinião
- Vida
- Social
- Desporto
- Entrevistas
- Investigação
- Vídeos
- Fotogalerias
- Contos Clássicos Portugueses
- Viajante
- Podcasts
- Arquivo SÁBADO
- Jogos
- Cartoon
- Ficção SÁBADO
- O Último a Rir
- C-Studio
- Especiais C-Studio
- SÁBADO LAB
- Europa Viva
Secções
Copyright © 2026. Todos os direitos reservados. É expressamente proibida a reprodução na totalidade ou em parte, em qualquer tipo de suporte, sem prévia permissão por escrito da Medialivre S.A. Consulte a Política de Privacidade Medialivre.